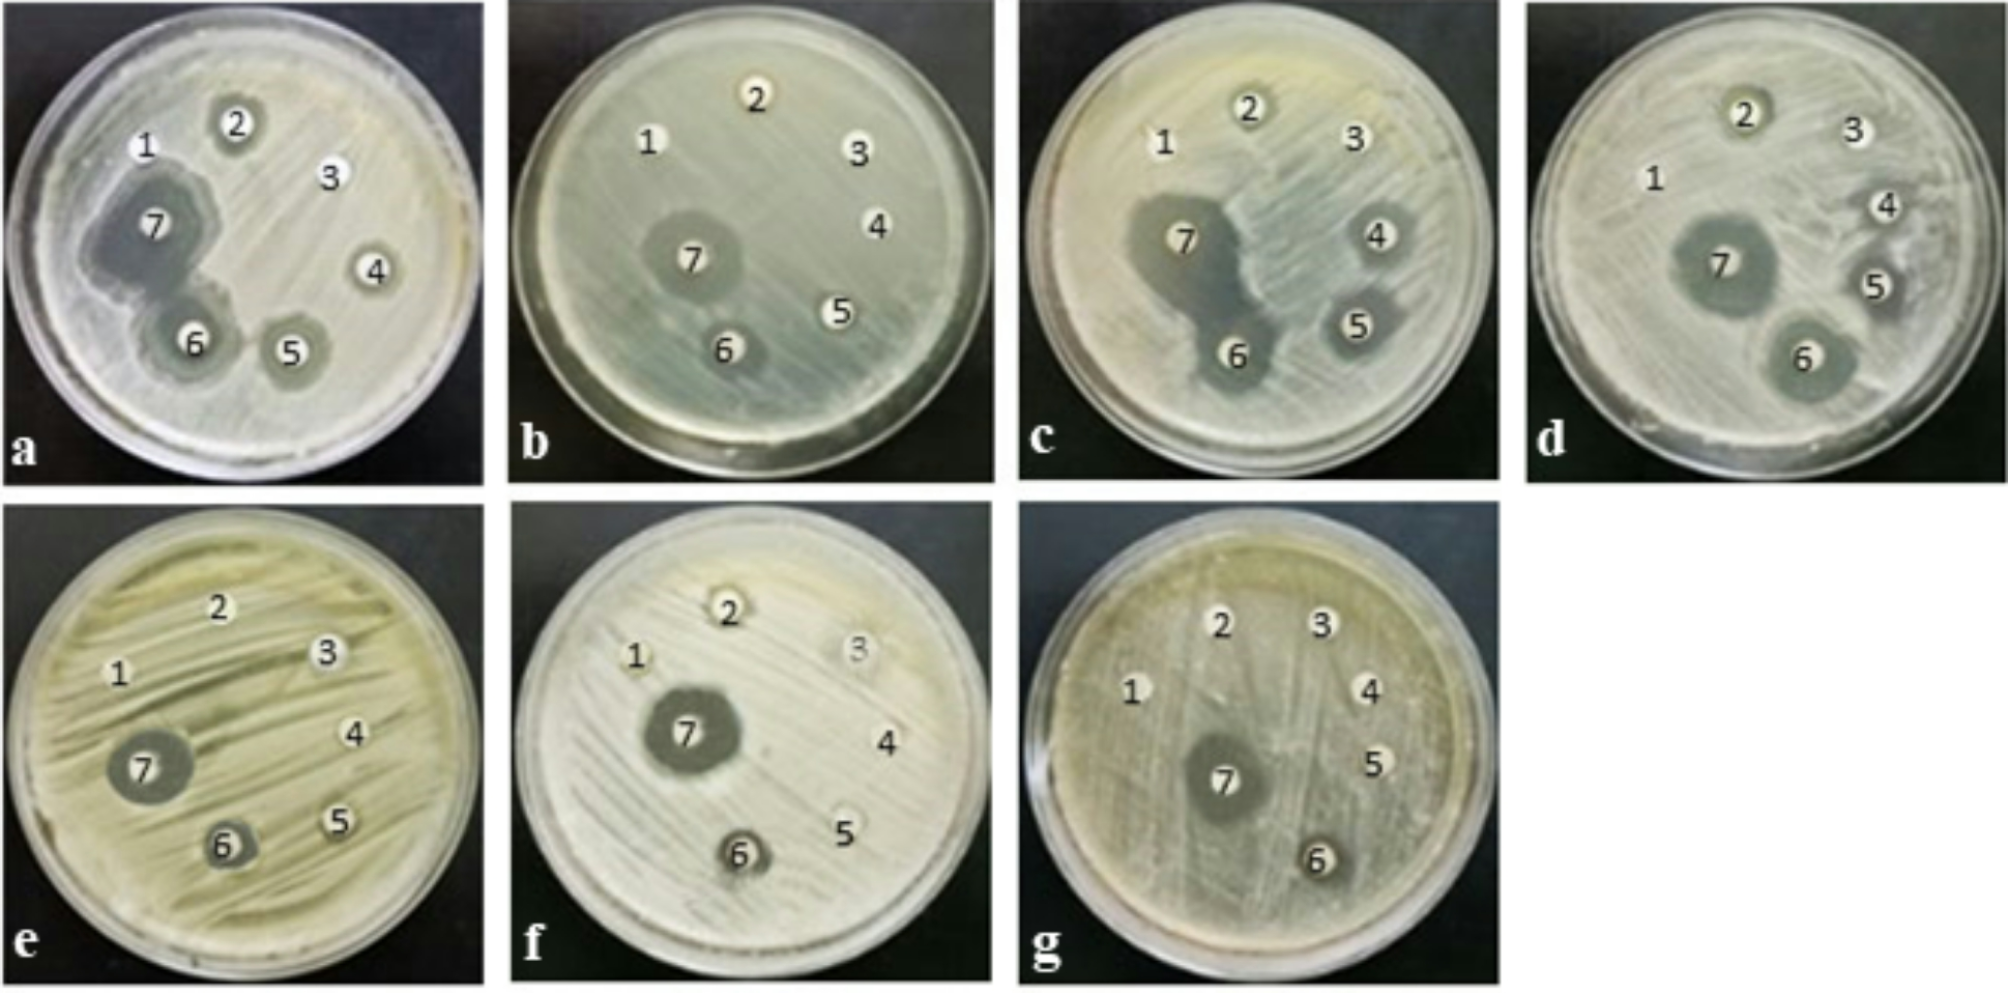
Fig. 7

Fig. 7
Antimicrobial activities of AgNPs: (a) E. coli, (b) P. aeruginosa, (c) B. cereus, (d) S. aureus, (e) C. albicans, (f) C. tropicalis, (g) G. candidum, (1) Fungal filtrate, (2) Positive control, (3) AgNO₃ (10 µg/mL), (4) AgNPs (5 µg/mL), (5) AgNPs (10 µg/mL), (6) AgNPs (25 µg/mL), (7) AgNPs (50 µg/mL).